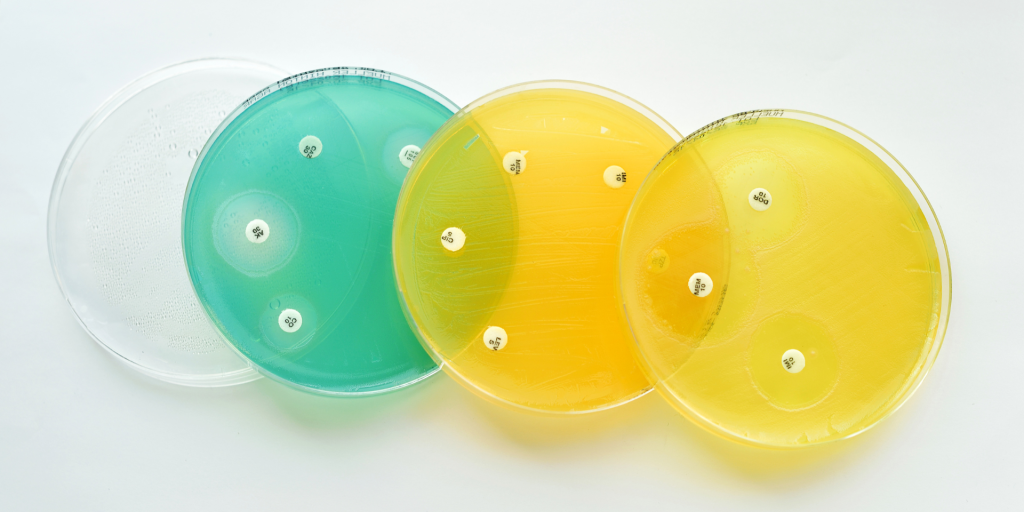

A Fundação de Amparo à Pesquisa do Estado de São Paulo (Fapesp) selecionou a pesquisa do médico infectologista e Professor da Unifesp, Arnaldo Lopes Colombo. O Programa Centros de Pesquisa, Inovação e Difusão (CEPIDs), da FAPES, financia projetos de pesquisa que abordam perguntas que transformam o conhecimento atual e cujos resultados possam ter impactos positivos para a sociedade. Os CEPIDs devem realizar pesquisas ousadas de excelência internacional em temas relevantes em sua área do conhecimento. O CEPID procura agregar pesquisadores em torno de questões de pesquisa fundamentais ou orientadas para aplicações para se transformar em um Centro de Classe Mundial em Pesquisa.
Foram anunciados os cinco novos Centros de Pesquisa, Inovação e Difusão (CEPIDs) que serão apoiados pela FAPESP por um período inicial de cinco anos, que poderá ser estendido, no máximo, por mais dois períodos de três anos. Os projetos foram selecionados entre as 38 propostas submetidas ao edital lançado em 2021, abrangendo as ciências de saúde, biológicas, agronomia e veterinária. A Universidade Federal de São Paulo (Unifesp) vai abrigar um CEPID dedicado a estudar a questão da resistência antimicrobiana, que compromete a eficácia da prevenção e do tratamento de um número crescente de infecções por vírus, bactérias, fungos e parasitas. O trabalho é coordenado pelo professor da Escola Paulista de Medicina Arnaldo Colombo.
“Considero um privilégio para qualquer pesquisador poder participar e ter protagonismo nesta força tarefa do CEPID que deverá ser instalado na UNIFESP, cujo o efeito deve ter grande impacto na resolução de questões fundamentais para a ciência e sociedade”, afirma o Prof Arnaldo Colombo.
Este trabalho contou com a colaboração de diversos pesquisadores da UNIFESP que atuam particularmente na Escola Paulista de Medicina, campus Diadema, campus São Jose dos Campos e de vários outros pesquisadores de universidades paulistas, como USP, UNICAMP e UNESP.
São mais de 50 pesquisadores envolvidos na proposta (entre pesquisadores e alunos), entre eles, o Prof Arnaldo L Colombo (Coordenador do CEPID), Profa. Ana Gales (Vice-coordenadora), Professora Soraya Smaili (Coordenação das atividades de Difusão), Professor Sergio Schenkman (Coordenação Científica em substituição do Prof. da Unicamp, Gustavo Goldaman) e Professor Moacir Miranda da FEA- USP (Coordenador de Inovação).
Importante mencionar que este CEPID envolve a articulação com cerca de 10 centros de pesquisa consolidados na área de resistência antimicrobiana localizados na Europa e nos EUA, parceiros na gestão pública (ANVISA, Ministério da Saúde, EMBRAPA) e do setor privado comprometido com o desenvolvimento de novas tecnologias em saúde.